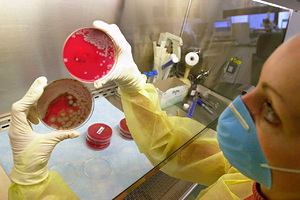
11-летний мальчик искупался в бассейне в Европе и не выжил из-за пожирающей мозг амебы

Bild: 11-летний мальчик не выжил после урока плавания в бассейне в СловакииАлександра Статных (Редактор отдела «Путешествия»)

Фото: Tom Mueller / imagebroker.com / Globallookpress.com
В Европе 11-летний мальчик искупался в термальном бассейне и не выжил из-за пожирающей мозг амебы. Об этом стало известно изданию Bild.
Уточняется, что инцидент произошел, когда ребенок посещал урок плавания на курорте Вадас в городе Штурово, Словакия. Через несколько дней у него диагностировали заражение простейшим организмом Naegleria fowleri, который также известен как амеба-убийца. Шансов на выживание у мальчика не было — официального лечения от поражения этим микроорганизмом нет.
Материалы по теме:
Страшнее коронавирусаОткуда взялись смертельно опасные бактерии и можно ли от них спастись10 февраля 2021

«Я не спал только когда ел и ходил в туалет»Загадочная болезнь приковала американца к постели. Через 11 лет он вылечил себя сам4 октября 2019
Врачи предположили, что амеба могла попасть в организм ребенка через назальные пазухи, а оттуда проникнуть в мозг. Внутри головы человека это простейшее распространяется, его жизнедеятельность вызывает припадки, галлюцинации и кому и в результате — летальный исход.
Сообщается, что поедающая мозг амеба — это теплолюбивое одноклеточное существо с плавниками, которое размножается при температуре выше 25 градусов и встречается в горячих источниках. После этого случая все термальные бассейны Вадаса закрыли для проведения лабораторной экспертизы.
Ранее туристка отправилась с мужем на остров Крит и заразилась опасной для жизни инфекцией. Женщине стало плохо через пять дней после приезда, затем она впала в кому.